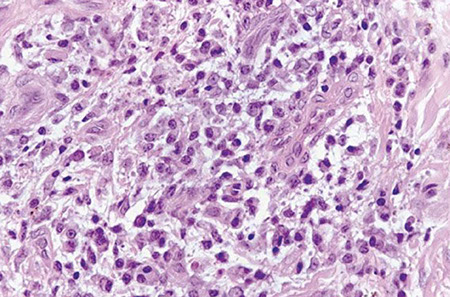

Nervous System Non-Tumor
Nervous System Reaction Patterns
Nervous System Disorders
Pediatric neuropathology
Acute Disseminated (post-infectious) Encephalomyelitis
Alzheimer disease
Amyotrophic Lateral Sclerosis (ALS)
Acute inflammatory demyelinating polyradiculopathy (AIDP; Guillain-Barre syndrome) - see Skeletal Muscle
Acute Hemorrhagic Leukoencephalopathy (AHLE)
Adrenoleukodystrophy
Cerebral Autosomal Dominant Arteriopathy with Subcortical Infarcts and Leukoencephalopathy (CADASIL)
Corticobasal Degeneration
Creutzfeldt-Jacob disease
Globoid leukodystrophy (Krabbes disease)
Hereditary Motor and Sensory Neuropathy (Charcot-Marie-Tooth disease)
Huntington disease
Lennox-Gastaut syndrome
Lewy body dementia
Machiafava-Bignami disease (MBD)
Mitochondrial encephalopathy c lactic acidosis and stroke-like episodes (MELAS)
Metachromatic leukodystrophy
Multiple sclerosis
Balo Concentric Sclerosis
Multi-infarct dementia
Multiple System Atrophy
Parkinson's disease
Pick disease
Non-Pick's FrontoTemporal Lobar Dementia (FTLD)
Progressive multifocal leukoencephalopathy (PML)
Progressive Supranuclear Palsy
Sturge-Weber syndrome
Transmissible Spongiform Encephalopathies
Tuberous Sclerosis (TS)
Vascular dementia
CNS infections
Neurodevelopment
Defects of Neural Tube Closure (NTD)
Myelomeningocele
Holoprosencephaly
Arnold Chiari malformation
Neuronal heterotopias
Down Syndrome
Fragile X
Porencephaly
Multicystic encephalopathy
Subdural hemorrhage
Subpial hemorrhage
Subependymal hemorrhage
Subependymal (germinal matrix) hemorrhage
Periventricular Leukomalacia (PVL)
Gray matter lesions
Kernicterus
Cerebral palsy
Nervous System Reaction Patterns
Myelin formation begins in uteri, occuring when oligo cell processes wrap around multiple axons (vs Schwann cells, which only wrap around 1 axon)
- "Superman cells" in white matter (not reactive) seen in kids less than 2 yo
Cell Rxns
Neurons
Acute ischemic cell change (red-dead neurons‘)
- Cytoplasmic eosinophilia with cell shrinkage and nuclear pyknosis.
Represents irreversible necrosis of individual neurons and is most often encountered in acute hypoxia-ischemia.
- pt must be alive for 8 hours to see this change
- large neurons in CA1 sector of hippocampus esp vulnerable, also Purkinje cells of cerebellum, and neurons layers 3-5 of cerebral cortex
-- CA2 is the resistant of hippocampus, resistant to hypoxia
Neuronal cytoplasmic alterations
Neurofibrillary tangles in Alzheimer's disease or the Lewy bodies in
Parkinson's disease reflect abnormal cytoskeletal elements. Accumulation of metabolic products occurs in storage diseases. Lipofuscin accumulation is a non-specific "aging" change (when not associated with ceroid lipofuscinosis).
Axonal reaction
Nerve cells respond to axonal damage with "central chromatolysis" of
neuronal perikarya and "Wallerian degeneration" of axon distal to site of injury.
Glia: Astrocytes
Astrocytosis = gliosis
Rxn to brain injury, results in fibrous astrocytosis (gliosis). Acutely
hypertrophic (gemistocytic) astrocytes are evident in early astroglial
reactions. Later stages of the reaction are dominated by an abundance of astrocytic processes – ie. glial scar
- ONLY time there is scarring with fibrous tissue in the brain is with an abscess
" Alzheimer type II astrocytosis"
a reaction of protoplasmic (gray matter) astrocytes may occur with systemic metabolic disturbaces (such as hyperammonemia associated with chronic liver disease.
- not actually assoc c Alzheimer dz (assoc c chronic liver dz), just named by same person
Glia: Oligodendrocytes
Degeneration results in local interruption in formation and maintenance of myelin (demyelination), resulting in impaired or blocked impulse conduction along axons. Specific oligodendrocyte injury due to a papovavirus occurs in progressive multifocal leukoencephalopathy (PML)
Infarct vs demyelination
Both have gliosis and lipid-laden macrophages
- myelin depletion on special stain
- Look for axons traversing the lesion, if there are axons traversing lesion then it is not an infarct, if there are no axons and red dead neurons, more likely an infarct
- NFP will stain axons so you can tell
Glia: Ependyma
Undergo necrosis – not replaced, leaving subependymal glial nodules.
Injury to ependymal cells causes a discontinuation of the ependymal lining, and also a reactive subependymal glial nodule
Microglia: Resident tissue histiocytes of the brain.
- bc they are histiocytes, they are CD68+
Activation results in morphologic transformation to so-called
"pleomorphic" or "rod-cell" microglia, which are capable of ingesting
destroyed neurons ("neuronophagia") or myelin.
- Fully developed macrophages occur with severe tissue destruction and with active demyelination. Perivascular histiocytes are antigen-presenting cells of the CNS.
Mass effect, edema, and herniation
With an expanding intracranial mass (edema, hemorrhage, tumor, abscess, etc.) the rate of expansion is critical. Slowly growing masses allow for compensatory changes and little neurological deficit until mass is large (eg. Meningioma) while rapidly growing masses (eg. acute hypertensive hemorrhage) may be rapidly lethal.
Brain Edema is accumulation of fluid within the brain as a result of various forms of injury; a major cause of brain swelling and herniation.
Vasogenic edema: Breakdown of blood-brain barrier due to disruption of tight junctions with leakage of protein, fluid and electrolytes into the extracellular compartment of brain.
MC type of edema - seen in trauma, tumors, infections, hemorrhage
and later stages of infarcts. More prominent in white matter.
- Occurs with tumor angiogenesis.
Cytotoxic edema:
Intracellular fluid accumulation causes swelling of the cellular elements themselves. Usually due to disruption of energy-dependent Na+/K+ membrane pump. Most important circumstance is diffuse cerebral ischemia when hypoxia/anoxia interfere with energy source for the Na+/K+ pump. Most pronounced in gray matter.
Interstitial edema: Passive periventricular fluid accumulation in
ventriculomegaly.
Herniation - consequence of mass increase within the protective but non-expansile skull
- brain is compartmentalized within rigid skull (in adults - after closure of sutures) by the falx and tentorium. Mass lesions (e.g. abscesses, tumors, hemorrhages, hydrocephalus, etc.) compress adjacent structures, displacing them - after CSF and blood volumes are first adjusted. Both the volume of the mass lesion itself, and added vol of any surrounding edema caused by the mass are additive.
Transtentorial herniation – Uncus and other mesial temporal lobe structures herniate around edge of tentorium cerebelli.
Uncal herniation - With a unilateral space-occupying lesion, structures shift downward resulting in the anteromedial portion of the temporal lobe moving over the adjacent ipsilateral free edge (incisura) of the tentorium cerebelli. Unless alleviated, the ultimate outcome is death. As it evolves, uncal herniation may lead to:
- Ipsilateral compression of CN3, especially the superficial parasympathetic fibers, leading to a dilated, fixed pupil on the side of the lesion (right sided herniation = right sided pupil dilation)
- Kernohan's notch: contralateral cerebral peduncle compression causes weakness of the opposite side
- Compression of reticular formation in midbrain, leading to
decerebrate rigidity and coma. (decerebrate posture: abnormal
body posture that involves rigid extension of the arms and legs,
downward pointing of the toes, backward arching of the head.)
- DURET HEMORRHAGE: Stretching or tearing of the small
branches of the posterior cerebral or basilar arteries supplying the
midbrain and upper pons, resulting in hemorrhages in these areas.
These are also known as "Duret hemorrhages".
- Ipsilateral compression of the posterior cerebral artery resulting in
medial occipital lobe infarction
- Hemorrhage or softening of the contralateral cerebral peduncle
(Kernohan's notch) as it is compressed against the contralateral
incisura, causing a hemiparesis ipsilateral (paradoxically) to the
lesion. ("False localizing sign").
Central herniation - symmetrical downward displacement, most importantly of hypothalamic and thalamic structures, due to generalized and/or symmetrical swelling of both hemispheres (e.g. with massive bilateral cerebral swelling in severe anoxia). Damage to diencephalon causes stupor.
Cingulate herniation - also called subfalcial herniation, refers to the
lateral shift of cingulate gyrus across the midline ("midline shift")
under the free edge of the falx cerebri, as a result of a unilateral space occupying lesion.
Cerebellar tonsillar herniation - Downward displacement of inferior
cerebellum 2/2 space-occupying lesion in posterior fossa or continued expansion of a large supratentorial lesion.
- Result is herniation of medial cerebellar tonsils through foramen magnum. Medulla is thereby compressed, resulting eventually in respiratory arrest.
- fatal if not corrected rapidly
Outward "transcalvarial" herniation - Outward displacement of swollen brain through a defect (traumatic) in the skull.
Hydrocephalus
Most often caused by obstruction of cerebrospinal fluid circulation or increased production. (CSF made by choroid plexus)
- Pattern of flow: From the lateral ventricles through the paired foramina of Monro to the third ventricle, then caudally through the aqueduct of Sylvius and fourth ventricle. CSF exits to the basal subarachnoid space through the paired lateral foramina of Luschka or the midline foramen of Magendie.
- Absorption: Mostly through the arachnoid villi in the dural sinuses.
Craniospinal Trauma
2 forms of injury can occur with trauma:
1) "Primary damage" at "moment" of injury. Contusion/laceration and
diffuse axonal damage are primary injuries.
2) "Secondary damage" is stuff like cerebral edema and herniation
- presence and volume of associated intracranial hemorrhage further alters the clinical course of brain injury.
- although inc intracranial pressure, hypoxia and brain swelling represent common complications in any significant head trauma, infection is a much greater risk in penetrating head injury than in non-penetrating injury.
Closed Head Injury: 2/2 direct contact at site of impact or indirectly from acceleration/deceleration forces acting on the head and brain, in which penetration of the skull does not occur.
1) Concussion: syndrome of transient alteration of consciousness from head injury, usually caused by change in momentum or rotational acceleration of the head. Pt may have loss of conciousness, temporary respiratory arrest, and loss of reflexes.
2) Brain Contusion/Laceration: Contusion/laceration injury of the brain results from direct contact at the site of impact and/or from relative movement of the brain inside the skull, related to acceleration/deceleration of the head. Contusion is a "bruise" of the brain. Laceration results from more severe tissue injury than contusion and is associated with tearing of the pial surface. The most superficial portions of the brain (crests of the gyri) undergo necrosis with eventual gliosis of adjacent tissue.
- contusions typically develop along crest of gyrus, and infarcts are centered at the base
-- "Coup" contusions: located directly beneath the site of traumatic contact of the head with an impacting object.
--"Contrecoup" contusions: Refers to contusions at tips and along
inferior-lateral surfaces of frontal and temporal lobes, resulting from shearing forces related to rotational movement of the brain "over" the underlying bony surfaces of anterior and middle fossae.
3) Diffuse Axonal Injury (DAI): 2/2 shearing/tensile forces acting on axons within the transiently distorted brain during head trauma caused by traumatic acceleration/deceleration. The patient may be comatose immediately after the traumatic event and remain in a persistent vegetative state. Lesser forms of DAI occur and the extent of axonal damage is an important factor in outcome following head trauma.
- Micro: Axonal swellings (spheroids) are typically found in
parasagittal white matter, corpus callosum, internal capsule, and in the
brainstem. Diffuse axonal injury results in the abnormal accumulation of many axoplasmic constituents
- earliest detectable protein: Amyloid Precursor Protein (APP), detected by IHC
- Brain stem dorsal quadrantic hemorrhage: Occurs with marked DAI; patient typically comatose at time of injury.
Traumatic Intracranial Hemorrhage: Effects depend, not only on volume, but also rate of accumulation, and origin/location
1) Epidural Hemorrhage: Results when skull fracture, involving temporal or parietal bones, crosses an arterial (usually the middle meningeal artery) groove, tearing the artery. Blood dissects between skull's inner surface and the outer dural surface. The patient may have a "lucid interval" between injury and herniation.
2) Subdural Hemorrhage: accumulation of blood in the "potential" space between the inner surface of the dura and outer surface of the arachnoid membrane; results from tearing of the bridging veins which pass through the subdural space to drain into the dural venous sinuses; seen in elderly and alcoholics (brain atrophy stretches bridging brains)
- occurs as a consequence of movement of the brain within the relatively fixed dura/calvarium during trauma.
- Acute: Blood accumulates relatively quickly, 2/2 large tears in bridging veins or in a dural venous sinus itself.
--- represents significant risk to pt 2/2 relatively rapidly developing "mass effect."
- Chronic: Although also initially the result of bleeding from torn bridging veins, there is more gradual accumulation of blood, which results from recurrent bleeding over weeks to months. When subdural hematomas organize, there is fibrovascular invasion of the hematoma from the dural surface. This results in a fibrovascular "neomembrane", which can grow to cause mass effect and herniation.
3) Subarachnoid Hemorrhage: Subarachnoid hemorrhage resulting from head trauma is a common phenomenon, usually assoc c contusion/laceration of the brain and/or subdural hemorrhage.
- 2/2 hypoxic-ischemic stress, blood from parenchymal (sub-ependymal) or ventricular (choroid plexus) hemorrhage, sepsis, coagulopathy
- may be caused by aneurysms
4) Intracerebral Hemorrhage: Bleeding within brain parenchyma is due to contusion/laceration or penetrating brain injury.
Penetrating Head Injury: Open/compound skull fracture or missile injuries directly injure brain tissue and can be further complicated by infection.
Spinal Trauma
- spectrum of traumatic injury to spinal cord is analogous to that in the cranium. At the level of an acute spinal injury, there may be hemorrhage, necrosis, and axonal swelling. The lesion tapers above and below the level of injury. Over time, liquefaction and cavitaion with axonal degeneration above and below the lesion result in postraumatic syryngomyelia".

Inflammation (blue arrow) and dead red neurons (yellow)


Reactions of neurons to injury, ependymal cells: granular ependymitis; subependymal glial nodules; general rxn of ependyma to injury is cell loss w/o regeneration; prolif of subependymal glia can protrude into ventricle

Microglia, CD68
Reactions of neurons to injury, Microglia: neuonophagia. Microglia aggregates around dying neurons; seen in viral infx


Aquaporins are channels that regulate the BBB

Edema around a hemorrhagic tumor






Papilledema
Edematous white matter
Subfalcial herniation
Uncal herniation - pushes CN3 -> inc parasymp -> ipsilat pupil dilation
Secondary brainstem hemorrhages

Cerebellar tonsillar herniation
Diffuse Axonal Injury - petechiae in corpus callosum


Epidural hematoma

Subarachnoid hemorrhage

Subdural hematoma

B-amyloid precursor protein (BAPP) can detect axonal injuries after 2-3 hours in DAI


Brain contusion


Reactive astrocytic gliosis c astrocytes highlighted by Glial Fibrillary Protein (GFAP)
Alzheimer type 2 astrocytes (arrows)

Nervous System Disorders
Acute disseminated (postinfectious) encephalomyelitis (ADEM)
Rare, a type IV HS that presents 1-3 wks after infx
- 2/2 multifocal perivenular inflam and demyelination after infx c measels or chickenpox or some vaccines
- sx are headache, vomiting, fever c rapid motor and sensory manifestation
Micro: multiple perivenous lesion in white matter c lymphs, foamy macrophages, some plasma cells around small veins and venules
- infiltrate extends to surrounding tissue and has zones of demyelination
- some axonal destruction can be seen c myelin loss
IHC: CD68 can highlight the histiocyte-rich perivascular fibrin deposition and hemorrhage, esp perivascular
Tx: Roids (IV) and Ig
Px: Recovery in 1-6 mo
Subacute Sclerosing Panencephalitis (SSPE)
Rare dz in kiddos and young adults
- caused by prolonged infx c measles virus in the CNS
- usually occurs 5-10 years after measles infx
- MC areas involved are periventricular and subcortical white matter
In early stages, see behavioral and personality changes
- later on see myoclonic jerks and convulsions
Alzheimer disease
MCC (~60%) of all dementias in elderly; up to 5% of people >65yo
- inc risk c trisomy 21 (inc ABPP gene), - seen in virtually all Down syndrome patients after the age of approximately 30 years
- 1/10 familial - Early onset (genetic): APP (cr 21 [Down syndrome]), presenilin-1 (cr 14), presenilin-2 (cr 1)
- Late onset: ApoE4 (cr 19); ApoE2 (c r 19) is protective bc is a chaperone protein that helps B-pleated sheet formation
Sx: defective aphasia, apraxia, agnosia, dec executive function, dec IQ (not normal)
- death usually w/in 10 yrs of dx
Gross: diffuse cortical atrophy; hydrocephalus ex-vacuo, pallor of locus coeruleus
Micro: dec ACh, Senile plaque (extracellular B- amyloid core) which can lead to amyloid angiopathy (amyloid surrounding vessels) and lobar intracranial bleeding (AB amyloid made by breaking up amyloid protein) -*** looks like someone put out cigarette in brain
- Hirano bodies: intracytoplasmic proximal dendritic eosinophilic inclusion of actin seen mostly in hippocampus
- Granulovacuolar degeneration (of Simchowitz)- accum of basophilic granules and small clear vacuoles in hippocampal neurons
- Neurofibrillary tangles (intracytoplasmic basophilic abnormally phosphorylated tau protein [microtubules]) -- correlate c dementia progression
NIA-AA Guidelines for Alzheimer disease diagnosis
- must rank 3 parameters: Amyloid, Braak, and CERAD to get an ABC score
A. Ab plaque score (modified from Thal et al [1]):
A0: no Ab or amyloid plaques
A1: Thal phase 1 or 2
A2: Thal phase 3
A3: Thal phase 4 or 5
B. NFT stage (modified from Braak for silver-based histochemistry or phospho-tau immunohistochemistry [Done at UF])
B0: no NFTs
B1: Braak stage I or II
B2: Braak stage III or IV
B3: Braak stage Vor VI
C. Neuritic plaque score (modified from CERAD)
C0: no neuritic plaques
C1: CERAD score sparse
C2: CERAD score moderate
C3: CERAD score frequent
Note: Although cerebral amyloid angiopathy (CAA), as well as capillary CAA, are not considered in these rankings, they should be reported.
Dx requires determination of plaque and tangle density in multiple brain regions
- makes you able to make determination of probability of Alz dz
IHC: AT8 (to see hyperphosphorylated tau), silver, thioflavin S
Genes:
1) Amyloid precursor protein (APP) gene, chr. 21; APP cleaved by
secretases to form the pathogenic AB-amyloid peptide, mutations of APP gene associated with early-onset familial AD
2) Presenilin 1 (PS1) gene, chr. 14; mutations of PS1 gene associated with early-onset familial AD
3) Presenilin 2 (PS2) gene, chr. 1
4) Apolipoprotein E (ApoE) gene, chr. 19; presence of the e4 allele
associated with sporadic late-onset AD
Alzheimer disease vs. Multi-infarct dementia
- other major cause of dementia in the elderly, multi-infarct disease, is not a "degenerative disease" but results from multiple infarcts. A clinically progressive form frequently involves small deep-seated "lacunar" infarcts, diffuse subcortical white matter degeneration
(Binswanger's disease), and /or focal gray matter infarcts. The latter are usually found in a setting of hypertensive cerebrovascular disease, with atherosclerosis of major cerebral blood vessels as well as hyaline
sclerosis of small arteries and arterioles.
- effects of neurodegenerative and vascular changes additive
Tx: memantine (NMDA agonist) and AChE Inhibitors (tacrine, donepezil, rivastigmine, galantimine)
Vascular (Multi-Infarct) dementia
2nd MCC dementia; 2/2 cerebral atherosclerosis and vascular insult
- multi-infarct: step-wise decline in cog function (Tx c coumadin / aspirin to prevent more infarcts), focal neurologic signs,
- assoc c syphilis, HIV, vit B12 def, Wilson's dz
dec BP and donepezil and memantine
Gross: medial thalamic infarcts
Binswanger's disease: Chronic HTN that leads to diffuse subcortical infarcts
Dimentia pugilistica - seen mostly in boxers or people c repeated head trauma; either way needs decades to develop
Amyotrophic Lateral Sclerosis (ALS)
Progressive, late-onset motor neuron dz 2/2 selective premature degen and death of upper and lower motor neuron in motor cortex, brainstem, and spinal cord
- loss of anterior horn cells in the spinal cord leads to atrophy and fibrosis in the motor (ventral) spinal roots
(anterior horn cells - "amyotrophic") and upper motor neurons (lateral corticospinal tract degeneration - "sclerosis").
- begins in early adult life, 6-7th decade, usually c fatal paralysis in 3-5 yrs from resp failure
- fairly prevalent (2/ 100k), higher in Pacific Islanders (Guam) and from Kii Peninsula of Japan (possibly from B-methylamino-L-alanine consumption
- if cause unknown, dx'd as sporadic ALS (SALS)
- 1/10 are familial (Familial ALS [FALS])
Bunina body - eosinophilic intraneuronal inclusions seen in anterior horn neurons in pts c ALS
IHC: TDP-43 inclusions sometimes
Genes: copper / zinc superoxide dismutase (SOD1) mutations; AD
- Hexanucleotide repeat disorder in some FTLD/ALS cases:
AD form of FTLD-U / FTLD-ALS has C9ORF72 mutations
(Chromosome 9 open reading frame 72)
Acute Hemorrhagic Leukoencephalopathy (AHLE)
Perivenular demyelination and diffuse hemorrhagic necrosis of CNS
- hyperacute form of acute disseminated encephalomyelitis
- rare
Px: high morbidity and mortality
Adrenoleukodystrophy
X-linked disorder c adrenal atrophy
Corticobasal Degeneration
- aka Rebeiz disease
Rare sporadic neurodegenerative dz c progressive asymmetrical involuntary movements, akinetic-rigid parkinsonism, and variable dementia
- Motor difficuties early in dz
Sx: dystonia, alien limb
Micro: Classic "ballooned" (big blue) neurons immunoreactive for phosphorylated neurofilament protein. Tau is positive in cell prossesses of gray and white matter.
- coiled bodies: rings of tau protein that surrounds oligo
Globoid Leukodystrophy (Krabbes disease)
Has some globoid cells
Hereditary Motor and Sensory Neuropathy (Charcot-Marie-Tooth disease)
Progressive hereditary nerve disorders caused by defect in peripheral nerve / myelin sheath protein production / function
- type I is Charcot-Marie-Tooth dz, affecting sensory and motor neurons
- Type II is axonal; and type III is Dejerine-Sottas syndrome
Micro: Onion-bulb formation
Genes: AD. assoc c duplication of a 1.5 Mb region of DNA on 17p12 containing the Peripheral Myelin Protein 22 (PMP22) gene
Hippocampal sclerosis
Severe neurodegeneration and atrophy without underlting cause
- dementia from amnesia
Huntington disease
AD trinucleotide repeat dz on cr 4p IT15 (HTT) gene c CAG repeats (***Caudate, ACh, GABA***)
- <28 repeats is normal phenotype, 28-35 considered premutation, 36-40 an allele with reduced penetrance, and >40 invariably assoc c dz
- strong correlation bwt paternal inheritance and early onset
- neurons die 2/2 NMDA-R binding and glutamate toxicity
- see atrophy of striatum (caudate nucleus and putament) ad frontal cortex
-- bc caudate borders lateral ventral ventricles, caudate atrophy causes hydrocephalus ex vacuo
- CAG deletions cause inc androgen sensitivity by causing androgen receptor mutations --> Benign Prostatic Hypertrophy
-- transcription factor of BDNF gene (normal pro-survivor factor) is decreased
Gross: atrophy of the caudate nucleus and putamen associated with a diffuse neuronal loss.
Sx Chorea, depression, progressive dementia
- symptoms show anticipation bwt generations and usually begin bwt ages 20-50
- MCC death is cardiomegaly
Genes: Huntington disease gene (HD) on chromosome 4 contains a polymorphic CAG trinuceotide repeat region that is greatly increased in patients with the disease.
- Clinical severity of the disease correlates with increasing length of trinucleotide repeats in successive generations ('anticipation')
Other trinucleotide repeat syndromes:
• Fragile X syndrome AND Fragile X tremor ataxia syndrome
• Myotonic dystrophy
• Spinocerebellar atrophies
• Spinobulbar muscular atrophy
• Dentatorubropallidoluysian atrophy
• Machado-Joseph disease
• Freidreich’s ataxia
• Kennedy‘s disease
Dx: Atrophy of caudate nucleus and >40 CAG repeats
Tx: dopamine antagonist (hal), reserpine, tetrabenazine
- SSRI's or TCA's for depression
Lennox-Gastaut syndrome
Pediatric disorder with multiple types of seizures, MR, and abnormal EEG findings
- have worse MR with earlier onset (bwt 1-2 yo), hx of West syndrome, more frequent sx, an identifiable etiology
Dx: EEG essential
- can use imaging to look for underlying cause
Tx: variety of medical (valproic acid) and surgical (corpus callostomy) tx options
ADEM
ADEM



SSPE

Amyloid angiopathy

Neuron with tangle, Hirano body and granulovacuolar degeneration

Granulovacuolar degeneration

Hirano body

Tau + neurofibrillary tangles in Alzheimer dz

ALS



Bunina body (BB); motor neuron c BB (arrow), which is eosinophilic, hyaline (glasslike) and fish-shaped
Small onion bulbs

Huntington disease

Machiafava-Bignami disease (MBD)
Rare, demyelination of the corpus callosum; assoc c chronic alcoholism
- rarefied corpus callosum, and some reactive changes
- originally described in Italian men that were drinking lots of red wine, that got hemorrhage into corpus callosum
Mitochondrial encephalopathy with lactic acidosis and strokelike episodes (MELAS)
Progressive neurologic deterioration after initially normal development
- deterioration begins with strokelike neurologic deficits (transient hemiparesis or cortical blindness), often accompanied by seizures
- Point mutations in the MT-TL1 gene, which is located within the mtDNA
Multiple System Atrophy
Group of 3 separate conditions c shared path features:
1: Olivopontocerebellar atrophy (OPCA)
2. Striatonigral degeneration
3. Shy-Drager syndrome: autonomic dysfunction, bladder incontinence
All conditions share glial cytoplasmic intranuclei a-synuclein
- nuronal cytoplasmic and intranuclear a-sunuclin inclusions
- not seen well on HE, must do immunostain
Gross: Striatonigral degeneration; Olivopontocerebellar atrophy
Parkinson disease
Neurodegenerative dz c Lewy bodies (intracytoplasmic pink bodies with clear halo made of a-synuclein) c depigmentation of substantia nigra pars compacta and locus ceruleus (2/2 loss of dopaminergic neurons)
- Lewy bodies found only in SNc, locus ceruleus, dorsal motor nucleus of vagus, and basal nucleus of Meynart in Parkinson's, but are widespread in Lewy body dz
- rarely linked to MPTP exposure in street drugs
Sx: pts get Tremors at rest, Rigidity, Akinesia, and Postural instability (***TRAP***)
- 3-5% of people over age 65 yo are affected
~ Wilson's dz also presents c Parkinsonism
- also may see progressive supranuclear palsy
- dec Dopamine and inc ACh
Genes: Mutated GBA gene for lysosomal enzyme glucocerebrosidase (same as in Gaucher's dz!!!)
- SNCA gene has also been implemented in familial cases
Tx
***BALSA***
Bromocriptine, promipexole, ropinirole
Amantidine inc dopamine secretion
L-dopa / carbidopa
Selegiline and COMT inhibitors (entacapone and tolcapone [dec dopa breakdown])
Antimuscarines (benztropine) and baclofen (tizadine) for spasticity
Lewy body dementia
Parkinsonism c dementia and visual hallucinations, anosmia (lots of Lewy bodies early on in olfactory bulbs), repeated falls and syncope
- REM sleep disorders are characteristic (punch spouse in sleep)
Micro: a-synuclein defect causes Lewy bodies (eosinophilic cytoplasmic accumulations) to be found all throughout cerebral cortex (NOT seen in Parkinson's dz)
IHC: a-synuclein and or ubiquitun
Tx: same as AD
Frontotemporal Dementias
- most c tau protein defects:
- includes Pick disease, non-Pick's FTLD, Progressive supranuclear palsy,
Pick disease (frontotemporal dementia [with Parkinsonism])
Rare, severe dementing disease characterized by marked frontal and temporal lobe atrophy
*** Pick your nose and your ears ***
Least common of tauopathies, but most unique
Dementia, aphasia, parkinsonian aspects, personality changes
- spares parietal and post 2/3 of sup temporal gyrus
- severe frontotemporal atrophy, "knife-edge" gyri
Micro: Pick bodies (round intracytoplasmic aggregated tau protein that stains c silver [same as in AD - except that it doesn't persist long after death?]) seen in hippocampal dentate gyrus and neocortex
- composed of subset of tau (3R) [3R unique???]
- massive neuronal loss and gliosis in frontal and temporal areas
- Pick bodies are sometimes + for ubiquitin
Genes: mutated MAPT gene that encodes the microtubule assoc protein tau
Non-Pick's FrontoTemporal Lobar Dementia (FTLD)
Group of dementia c shared features
- seletive frontal and temporal lobe atrophy (15-20% of dementi)
Behavioral variant
Semantic dementia
Progressive nonfluent aphasia
5 main subtypes:
FTLD-tau (50%)
FTLD-TDP (45%)- may also have ALS
FTLD-FUS (5%)
FTLD-U
FTLD-NI
Frontotemporal lobar degeneration with ubiquitin inclusions (FTLD-U)
- non-Alzheimer neurodegenerative dz c Ubiquitin and TDP-43 inclusions (no tau or A beta amyloid).
- TDP-43: Transactive response (TAR)-DNA-binding protein with a
molecular weight of 43 kDa; is major dz protein in FTLD-U and ALS (amyotrophic lateral sclerosis)
- AD form of FTLD-U has C9ORF72 mutations (Chromosome 9 open reading frame 72) (hexanucleotide repeat) that show widespread TDP43 inclusions, esp in neocortex and hippocampus AND ubiquitin/P62 inclusions in cerebellum.
- Non- TDP43 FTLD-U or FTLD-ALS may have abnormality of RNA
binding protein FUS
Progressive Supranuclear Palsy (PSP)
- aka Steele-Richardson-Olszewski syndrome
Tauopathy c unique clinical presentaion
- xial rigidity, supranuclear gaze palsy (opthalmoplegia), dysathria and dysphgia, cog dysfunction late on
- Sporadic disorder with parkinsonism, pseudobulbar palsy, supranuclear ophthalmoplegia, and congnitive decline
Gross: depigmentation of substantia nigra, atrophy of brainstem
- humminhbird and Mickey Mouse signs
Mico: Globose tau tangles in cortex, SNc, basis pontis, cerebellar dentate nucelsu, globus pallidus, subthalamic nuclei, grumous degeneration of the dentate
Sturge-Weber Disease
• Encephalotrigeminal angiomatosis
• Unilateral lesions, no familial predisposition
• Facial port wine stain/Nevus flammeus of face, especially trigeminal nerve region
• Ipsilateral leptomeningeal venous angiomas
• Calcification of superficial cortex, underlying angioma, “tram tracks”
• Hemihypertrophy of skull
• Cortical atrophy, hemiparesis, contralateral hemiatrophy of body
• Seizures, retardation
Tuberous Sclerosis (TS)
AD
TSC1, 9q34, hamartina
TSC2 (MC) 16p13.3, tuberin
- TSC2 expression leads to inc mTOR activity
-Pulmonary Lymphangioleiomyomatosis (Lung disease of young women, Prolif of perivascular epithelial cells that express melanocytic and sm muscle cell markers)
-Subependymal giant cell astrocytomas (SEGA)
- cardiac rhabdomyomas
- renal angiomyolipomas, clear cell "sugar" tumors, lymphangioleiomyomatosis
-Tubers (cortical and subependymal glioneuronal hamartomas)
- rectal microhamartomatous polyps
- dermal angiofibromas (adenoma sebaceum) of face, subungual fibroma, ash-leaf patches
***TRASH SMASHAR (TS)***
Tuberin (regulates protein translation and cell growth)
Rhabdomyomas cardiacas - nearly 100% specific for TS
Angiomyolipomas in kidney that cause flank pain
Subependymal GC astrocytoma: "candlestick dripping" in ventricles
Hamartomas
Seizures (infantile spasms)
Mitral regurg
Ash-leaf spots (hyperpigmented skin lesions
Shagreen patches - rough papules c orange peel consistence c Wood's lamp
Hamartin (regulates neuronal synapse formation) and tuberin heterodimers
Adenoma sebacum - red brown papules on nose and cheeks c butterfly pattern
Rapamycin (sirolimus) decreases seizure freq and subepi GC size
Marchiafava-Bignami disease



Left is normal substantia nigra, right is Parkinsons c dec neurons
Lewy body

Lewy body

Neuropathology of Pick’s disease. Pick bodies (arrows) in frontal cortex. (A,B) Hematoxylin–eosin; (C,D) tau immunostaining.


PSP with globose tangles in subthalamic nucleus in background of grumous degeneration of the dentate

Cortical tuber
Balloon cells characteristic of TSC tuber

CNS Infections
Purulent (suppurative) Meningitis
Occurs after trauma, bacteremia (suppurative lesions of lung), direct extension (sinusitis, mastoiditis secondary to otitis media), facial cellulitis.
- overall, Strep pneumo is the MCC, can occus in infants up to adults
Common organisms:
Neonates:
Birth to 30 days: E. coli, Group B Streptococcus, Listeria monocytogenes (things that can be acquired in birthing process)
30-60 days: Group B Streptococcus
Infants to six years: S. pneumoniae, Hemophilus influenza (less cases due to vaccine)
Adolescent to young adult: Neisseria meningitidis, Streptococcus pneumoniae
Middle age - elderly: Streptococcus pneumoniae
Stages of Inflam:
1) Hyperemia of meningeal vessels and mild to mod cerebral edema
2) Fibrinopurulent exudate accumulates in subarachnoid space, around blood vessels, and in the Virchow-Robin space. Neural parenchyma normal at this stage.
3) Complications:
- Subarachnoid arteries and veins may thrombose causing cortical
ischemia/infarction. Cortical scaring may cause seizures.
- Inflammation may reach ventricles causing acute ependymitis or involve cranial nerves as they pass through the subarachnoid space causing cranial nerve deficits (e.g., hearing loss)
- Hydrocephalus may result from obstruction of CSF.
4) Meningococcal Meningitis:
- In adolescents and young adults Neisseria meningitidis often occurs in epidemics, especially in the context of close living quarters (college dorms, military barracks, day care centers etc.). The portal of entry is the nasopharynx.
- Disseminated meningococcemia - Waterhouse-Friderichsen syndrome can occur. This includes adrenal cortical necrosis, vasomotor collapse, septic shock, diffuse petechial skin rash.
- If patient dies acutely, there will be minimal purulent exudate; brain will appear congested and edematous.
Brain Abscess
Can Mimic Tumor (ring enhancing); comes from Sinusitis / mastoiditis secondary to otitis media (access to brain may be through retrograde thrombophlebitis.; Penetrating wounds or contaminated surgical wounds; Hematogenous (MCsource, especially from suppurative bronchopulmonary infections. Cyanotic heart disease in children appears is a predisposing factor)
- Abscesses as a complication of mastoiditis are commonly located in temporal lobe or cerebellum; while sinusitis may lead to abscesses in frontal lobe; and hematogenous spread (most common) results in abscesses within the distribution of the middle cerebral artery. These may occur at gray-white junction.
- Common organisms: Anaerobic or microaerophilic streptococci, staphylococci, bacteroides and various gram negative bacilli. Opportunistic organisms may cause abscesses in chronically debilitated or immunosuppressed patients.
- is one of the only times where can see true brain fibrosis
Micro:
- Early phase: Small necrotic focus with infiltration by PMNs (focal
"cerebritis")
- Fully developed lesion:
i. Central area of purulent exudate.
ii. Intermediate area of granulation tissue, which contains capillaries,
inflammatory cells, and proliferating fibroblasts.
iii. Collagenous connective tissue encapsulates the exudate.
iv. The surrounding brain parenchyma is usually edematous and shows a variable degree of gliosis.
v. The surrounding edema may be significant, leading to increased
intracranial pressure, herniation and death. Death may also occur from
rupture into ventricles with ensuing ventriculitis and meningitis.
CNS Mycobacterial infection
Tuberculosis meningitis
Typically involves the base of the brain with a thick gelatinous exudate adherent to brain. There is a greater frequency of arterial inflammation and thrombosis with infarction, higher incidence of ependymitis and cerebritis, and more extensive meningeal fibrosis leading to hydrocephalus
- can see granulomas
Miliary tuberculosis
Multiple small granulomas of brain and meninges. Microscopic to a few
millimeters in size. The granulomas have central caseation, multinucleated giant cells, lymphocytes, plasma cells, and histiocytes.
Tuberculoma
Solitary large encapsulated granuloma with central caseation
Pott's disease
Tuberculosis of the vertebral bodies or intervertebral discs; may be complicated by epidural abscess or vertebral collapse
Neurosyphilis
Brain infx occurs in ~1/10 untreated cases. Can see lots of plasma cells, and endarteritis obliterans
- initial infx probably always meningeal. This may lead to:
1. Meningeal neurosyphilis - a lymphocytic meningitis. May remain
asymptomatic. Occurs to some extent with other forms of neurosyphilis.
2. Meningovascular neurosyphilis. Secondary arteritis (syphilitic - "Hubner's" - endarteritis), with thrombosis,and ischemia of brain and spinal cord. Infarction occurs when major cerebral vessels are affected.
3. General paresis - "dementia paralytica". Chronic encephalitis with meningeal inflammation, brain atrophy, hydrocephalus, nerve cell loss, reactive astrocytosis, and proliferation of elongated "rod cell" microglia.
4. Tabes dorsalis - degeneration of dorsal root ganglia and posterior columns. Charcot joints are frequent in this type of neurosyphilis, is a neurogenic form of arthritis c loss of position sense
5. Congenital syphilis - T. pallidum may be transferred transplacentally during last 5 months of pregnancy.
Fungal infections
Most CNS fungal infections are opportunistic. They may occur in AIDS, hematologic or lymphoreticular disease, immunosuppressive therapy, and in diabetes. Amount of granulomatous reaction inversely proportional to immunosupression.
Cryptococcosis
Cryptotococcus neoformans. MCC fungal meningitis, usually with an insidious onset (often in non-immuno-compromised patients). May also cause focal lesion ("cryptococcoma"). CSF PCR now used for clinical
diagnosis. Roughly spherical yeast forms with mucicarmine-positive capsule.
- brain is slimy bc crypto organisms has mucoid rim
- bubbly basal ganglia bc organisms follow Virchow-Robbins spaces
Candida
CNS involvement in immunocompromised host c disseminated microabscesses. Small hyphae and yeast.
Rhinocerebral mucormycosis
Occurs in diabetic ketoacidosis. Usually enters via the paranasal sinuses - angioinvasive - leading to hemorrhagic infarcts. Fungial hyphae form 90 degree angle branches and are large, non-septate, and of non-uniform diameter.
Aspergillosis
Often disseminated in immunocompromised host, but may form fungus ball. Also angioinvasive and may lead to multifocal hemorrhagic
brain infarcts. Branching (45 degree) septate hyphae of uniform diameter.
Coccidioidomycosis: (Coccidioides immitis)
- seen in arid regions of southwestern US, Mexico and South America
- Infective arthrospores spread by inhalation of soil dust
- primary lung infection (usually mild and self-limited), with secondary spread to CNS in immunocompromised hosts or during pregnancy
- Large spherules (sporangia) with a thick, refractive capsule
Histoplasmosis
Obligate intracellular (found in macrophages) - small; may
mimic Toxoplasma
Parasitic Infections
Toxoplasmosis
Infx by Toxoplasmosis gondii is MCC of focal mass lesion in AIDS (differential diagnosis: CNS Lymphoma).
- sx usually subacute (1-2 weeks)
- Micro: Foci of necrosis, acute and chronic inflammation with both free
tachyzoites and encysted bradyzoites at the lesion periphery.
Congenital Toxoplasmosis: Transplacental transmission, Severe brain destruction c necrosis, calcifications, hydrocephalus, chorioretinitis -severe mental retardation.
Cysticercosis
- causative organism: Cysticercus cellulosae: Larval form of pork
tapeworm, Taenia solium. MCC of expanding intracranial mass lesion in young adults in Mexico. Causes cystic nodules in meninges and/or brain parenchyma. Rupture of the cyst may cause acute inflammatory reaction containing eosinophils and producing acute change in neurologic status.
Malaria
- most important parasitic disease in man, affecting 100 million persons worldwide. Plasmodium falciparum - most commonly has cerebral involvement often leading to death from cerebral necrosis and edema. A particular pattern of brain involvement called "hemorrhagic leukoencephalitis" is occationally observed.
Cerebral blood vessels get plugged c parasitized RBCs, c dots of hemozoin pigment, causing stasis and hypoxia
- Durck granuloma: ring hemorrhages and small collections of inflam cells
Amoebic infections
Primary amebic encephalitis
(Naegleria fowlerii) rare but nearly always fatal infection acquired by swimming or diving in non-flowing ponds, natural of man-made lakes, or improperly chlorinated hot tubes. Produces a rapidly progressive necrotizing meningoencephalitis. Amoebas enter the nasal cavity
and migrate through the cribriform plate and into the brain. Inferior frontal lobes are most affected.
- Naegleria fowleri: can look like macrophages on histo
Granulomatous amoebic meningoencephalitis
- Focal mass lesions in immunocompromised host.
- Caused by Acanthamoeba/Balamuthia species: form cysts in tissue.
Viral Infections
- is usually some degree of lymphocytic meningitis and perivascular lymphocytic inflammation (Virchow Robin space).
- Neuronal destruction with microglial nodules and gliosis.
- Some, but not all show a characteristic viral cytopathic effect.
Herpes simplex encephalitis
MCC sporadic encephalitis in the USA; results in severe acute
necrotizing encephalitis, asymetrically involving the temporal lobes with extension to frontal lobes; can be hemorrhagic
- Cowdry type A intranuclear inclusions are identified in neurons
and glial cells. Virus can also be specifically identified by IHC c antibody to Herpes simplex.
- Virus has been isolated from sensory (trigeminal, dorsal root) ganglia of normal individuals at autopsy. Virus enters CNS through nerves and may remain latent for years.
Herpes zoster (Varicella-zoster virus, "shingles")
- Factors such as stress and/or neoplasm have been associated with reactivation of latent virus.
- severe sensory symptoms, especially pain in characteristic dermatomal distribution
Cytomegalovirus:
- Disseminated CMV assoc c AIDS or other immuno-suppression.
- Also arises as congenital infection
- CMV shows predilection for ependymal cells with infected cells
- prominent, intranuclear inclusions.
- Spinal cord infection (myelitis) may also occur.
Rabies
RNA virus contracted from bite (or open skin exposure)
-Virus replicates locally in skeletal muscle and ascends to the CNS via
peripheral nerves
- sx free interval may last from weeks to months
- Characteristic intracytoplasmic inclusions - Negri bodies (also called Lyssa bodies), best seen in large neurons such as cerebellar Purkinje cells in cerebellum
Poliomyelitis
- Following ingestion, this enterovirus replicates in lymphoid tissue of the intestine, leading to viremia
- Invades the CNS bringing about selective destruction of lower motor neurons ("neuronophagia"), especially anterior horn cells, resulting in profound weakness
Progressive Multifocal Leukoencephalopathy (PML)
Opportunistic infx caused by reactivation of DNA Papovavirus - (JC virus)
- Demyelination due to lytic infection of oligodedrocytes
Micro: Intranuclear inclusions in oligodendrocytes (rare for oligos to be affected)
- Bizarre-appearing astrocytes (also infected), have glassy look to them
- Frequently seen in immunocompromised patients; little if any inflammation in typical cases - However….
- In the immune reconstitution syndrome a patient who had PML when HAART therapy initiated will have striking inflammatory white matter changes associated with PML.
Micro: Moth-eaten demyelination of CNS c oligodendroglial inclusions and destruction of oligos
- assoc c JC virus and seen in some (up to 4%) of AIDS pts
- degenerative atypia in astrocytes can be p53 (+) and can mimic an astrocytoma
IHC: (+) stain for JC virus in oligodendroglial cells, (+) p53 in reactive astrocytes
Px: rapidly progressive and fatal
AIDS
- HIV enters the central nervous system, in many, if not all cases, quite early in the infection. Infection may be subclinical or present as aseptic meningitis. In pre- HAART era up to 50% of patients with AIDS developed neurologic disease. At autopsy >80% of patients had neuropathologic findings. Nervous system pathology in AIDS may due to primary HIV infection or secondary infection by opportunistic agents.
Primary HIV infection:
- HIV ("giant cell") encephalitis: pts deterioration termed "AIDS dementia complex"
-- primary target cell however appears to be the monocyte. The virus enters the CNS via these cells ("Trojan Horse" hypothesis) and then replicates.
- Micro: Variable perivascular mononuclear infiltrates, microglial nodules and prominent gliosis. Changes most prominent in white matter. Multinucleated giant cells are pathognomonic for HIV
encephalitis.
- AIDS-related myelopathy, neuropathy and myopathy: Degeneration of posterior and lateral white matter columns in "vacuolar myelopathy". Several clinical syndromes of spinal cord involvement. peripheral neuropathy or myopathy have been reported in association with AIDS.
Opportunistic brain infections:
- Cerebral toxoplasmosis
- Cytomegalovirus: (Most common opportunistic pathogen)
- Progressive multifocal leukoencephalopathy (PML)
- Candidiasis and Cryptococcosis are most common
- Mycobacterium avium intracellulare (meningitis)
Prion Diseases (Spongiform Encephalopathies)
Key concepts: Transmissible proteinaceous agent is the prion
- No nucleic acid component; Very long incubation periods
- No antigenic or lymphocytic inflammatory response
- Prion protein is normally produced in a variety of tissues.
- Prion gene (chromosome 20p) encodes protein known as "PrP"
- infections form - " PrP scrapie " has undergone a conformational change (misfolded proteins) resulting in marked resistance to chemical and thermal inactivation.
- Selective vulnerability of specific neuronal populations in different diseases (some principally motor diseases, others dementing)
Specimens for spongiform encephalopathy should be placed in formalin in the OR, and then fixed in formic acid to render it as harmless as possible
- if tissue taken during autopsy, should be frozen and sent to the National Prion Disease Pathology Surveillance Center assoc c th CDCP
Triad: 1) Spongiform change, 2) neuronal loss, 3) gliosis
2/2 buildup of abnormal forms of proteins normally found in cells, known as Prion Proteins (PrP)
- gene for PrP, PRNP found on cr 20
- variations include Creutzfeldt-Jakob dz (CJD), Gerstmann-Straussler-Scheinker disease (GSS), fatal familial insomnia (FFI), and kuru
- kuru and CJD are contracted, whereas GSS and FFI are inherited
- causes loss of synapses, gliosis, neuronal death, microvacuolization, and spongiform change
- items used for handling instruments assoc c a spongiform encephalopathy should be placed in 2 N sodium hydroxide for an hour
Creutzfeldt-Jakob disease (subacute spongiform encephalopathy)
Rapidly progressing dementia, myoclonus (sudden spasm of a muscle or group of muscles), characteristic EEG findings. that kills in about 9 months
- may be genetic, sporadic or transmitted
- 85% sporadic (1 person per million)
- 10-15% of cases are inherited mutations of PrP gene
- < 1% are iatrogenic (cadaveric growth hormone injections; dura, cornea, pericardial grafts; neurosurgical instruments)
- Death in 6 months from onset
Sx: seizures, psychiatric disturbances, motor sx
Micro: Spongiform cortex c astrogliosis, amyloid plaques of Prp protein
- prions (a helix to B sheet [that is resistant to proteases and heat])
- neuronal loss, and reactive astrocytosis
- inc CSF14 3-3 protein
Gerstmann-Straussler-Scheinker Disease
- Rare, dominantly inherited a mutation in the PrP gene
- Progressive ataxia due to cerebellar involvement
- Prion protein amyloid plaques in cerebellum, cerebrum, brainstem
Kuru
- seen in Papua, New Guinea in the 1920's-1950's. Probably similar to
CJD but transmitted by ritual cannibalism.
Fatal Familial Insomnia
A recently described variant of prion disease that affects the thalamus and deep nuclear structures. It is caused by a specific genetic mutation of the prion protein gene
New variant CJD:
A new variant of prion disease, first reported in the United Kingdom, that affects younger individuals in their 20's-40's (versus older individuals with CJD). The disorder has been associated with the consumption of contaminated British beef during the "bovine spongiform encephalopathy" epidemic in the UK during the mid to late 1980's.
- have "daisy plaque"
Inclusion body myopathy ? May be prion disease of muscle.
Toxic-Metabolic Disease
Cerebrohepatic disorders
General response to hyperammonemia: Alzheimer type II astrocytes. Large, pale nuclei with peripheralization of nuclear chromatin, minimal cytoplasm. Protoplasmic astrocyte is the CNS cell metabolizes NH3.
Kernicterus
Occurs in some cases of erythroblastosis fetalis (Rh, ABO), and occasionally in jaundiced premature babies.
- Yellow pigmentation (bilirubin) is found in varying degrees in basal ganglia, thalamus, hippocampus, inferior olivary nuclei, subthalamic nuclei, and dentate nuclei. Nerve cell loss and gliosis.
- Escape of unconjugated (indirect) bilirubin into CNS
-- Liver: inability to conjugate excess bilirubin
-- CNS: blood brain barrier is more easily damaged
Wilson's Disease (Hepatolenticular Degeneration)
AR; Abnormal copper metabolism with increase of copper in liver. Coarse tremor of extremities, usually seen in children. May also have dementia. Accumulation of copper in Descemet's membrane in cornea, producing Keyser-Fleischer ring.
Gross: Degeneration of putamen due to copper deposition. Changes associated with hepatic dysfunction secondary to cirrhosis (such as
Alzheimer II cells, etc.)
Inborn Errors of Metabolism
GM2 Gangliosidosis (Tay-Sachs Disease)
Mutations on cr 15 leads to deficiency of hexosaminidase A, which breaks down gangliosides (sphingolipids). Excessive amounts of GM2 ganglioside accumulate in neurons, leading to abnormal neuronal storage.
MC in Eastern European Ashkenazic Jews, but has been described
in other ethnic groups.
"Cherry red spot" - macula is red, rest of retina is pale, due to abnormal storage in retinal ganglion cells (seen in other gangliosidoses and lipidoses).
-- cherry red spot also seen in Niemann-Pick dz, and central retinal artery occlusion
- cherry red spot may be 2/2 loss of transparency of posterior pole of the retina
Metachromatic leukodystrophy (MLD)
MC leukodystrophy, presents in infancy and lethal in a few years, hereditary (AR) ataxia caused by lysosomal dz (MC is arylsulfatase A def)
- "metachromatic" bc take stain of one color and turns it into something else
-- inc sulfatides causes impaired myelin sheath production
Gene: Mutation on chromosome 22q leads to a deficiency of arylsulfatase A, an enzyme that cleaves sulfate from sulfate-containing lipids (sufatides).
- Myelin loss diffusely affects the deep white matter with sparing of white matter fibers just beneath the cerebral cortex (subcortical U-fibers). This pattern of abnormal myelination is typical of most leukodystrophies.
Krabbe's leukodystrophy
Deficiency of galactocerebroside-beta-galactosidase due to gene mutation on chromosome 14q31. Accumulation of galactosylsphyngosine in enlarged macrophages within perivascular spaces within the white matter produces socalled "globoid cells"
Adrenoleukodystrophy
X-linked; Parieto-occipital demyelination;
- Adult form involves spinal cord and peripheral nerves.
- Peroxisomal disorder: defect in peroxisomal membrane protein that imports acyl coenzyme A synthetase into peroxisome
Nutritional Deficiency Diseases
Thiamine (Vitamin B1)
Thiamine deficiency may lead to the slowly evolving clinical disorder called beriberi. Deficiency may develop with chronic alcoholism and other nutritional deficiencies (protracted vomiting, anorexia nervosa)
- “ Wernicke-Korsakoff syndrome” reflects the fact that these two disorders often coincide, especially in patients coming to autopsy.
- Micro: Acute cases may have hemorrhages around the third ventricle
and aqueduct of Sylvius. The mammillary bodies are especially vulnerable. Chronic cases may show shrunken mammillary bodies which are brown due to hemosiderin deposition.
Vitamin B12 - Subacute Combined Degeneration of the Spinal Cord (SCDSC)
Degeneration of lateral and posterior columns and corticospinal tracts of spinal cord.
- Similar to pattern of HIV Myelopathy
SCDSC with degeneration of white matter in posterior and lateral funiculi of the spinal cord. The degenerated fibers lose their myelin and are thus unstained
Toxic Effects on the Nervous System
Alcohol (ethanol)
- Peripheral neuropathy - distal, chiefly sensory, involvement of axons, with secondary myelin loss.
- Alcoholic cerebellar degeneration – preferentially involves anterior and superior vermis, with truncal ataxia, broad-based gait.
- Central pontine myelinolysis
First described in alcoholics, but has also been seen in other settings
(including in renal transplant recipients). 2/2 rapid over-correction of hyponatremia, with development of mild brain edema, which primarily affects the base of pons, damaging the myelin.
- Nutritional deficiencies - see Wernicke-Korsakoff syndrome, peripheral neuropathy.
Methanol (methyl alcohol) - causes blindness, due to degeneration of retinal ganglion cells, also causes metabolic acidosis. A major metabolite of methanol is formic acid, which is believed to play a role in retinal toxicity.
- Selective putaminal necrosis and focal white matter changes may also be seen with severe exposure.
Carbon Monoxide
- Has strong affinity for hemoglobin (100 times more than oxygen!)
Carboxyhemoglobin (bright red color), decreases oxygen carrying capacity of the blood resulting in anemic hypoxia.
- Acute death: brain (and other tissues) are bright red, with congestion and petechiae in the white matter.
Delayed death: Neuronal necrosis in cerebral cortex. Bilateral necrosis of globus pallidus (characteristic) White matter destruction often extensive.
Cerebrovascular Disease
Generalized hypoxia
Selective vulnerability reflects intrinsic variations in susceptibility to hypoxia among different CNS cell types and between different types
of neurons:
1. Cell types arranged from most to least vulnerable:
neurons > oligodendrocytes > astrocytes > endothelium
2. Most vulnerable neurons: Sommer's sector (CA1) - hippocampus, Purkinje cells of cerebellum, cerebral cortical layers 3, 5, & 6
3. Specific areas - watershed zones (end-artery regions of arterial supply)
4. Severe injury - Respirator Brain - (Brain death with autolysis):
-- Extensive neuronal loss throughout the cerebrum (especially under such circumstances the necrotic brain will undergo gradual autolysis
despite the fact that patient is being kept alive by mechanical ventilation. This state, called respirator brain is an effect of brain autolysis, not an effect of the respirator.
Cerebral infarction
– ischemic-thromoembolic 70% of all “stroke”:
- circumscribed focus or area of brain tissue that was rendered nonviable as a result of localized hypoxia-ischemia from cessation of blood flow ; emboli usually come from the carotids
- embolic strokes are much more hemorrhagic, bc embolus degrades
Incidence: 70 per 100,000 persons between the ages of 45 and 55 years; 2 per 100 persons 85 years or older
Location: well-defined vascular territories of major cerebral vessels
- Male > Female (highly dependent on risk factors)
- Risk factors: diabetes, hypertension, smoking, family history,
hyperlipidemia, obesity
Gross: Acute cerebral infarct: focal swelling and congestion in a well-defined vascular territory
- Subacute: circumscribed regions of congestion, softening, and early
cavitation with separation of cortex from the underlying white matter
- Chronic (remote) infarct: complete cavitation with sparing of the subpial layer of cortex
Micro: Acute changes (12 to 24 hours after significant hypoxia-ischemia): tissue pallor with acute neuronal necrosis—eosinophilic (ischemic) cell change (red dead neurons)
Subacute changes (2 days to 2 weeks): appearance of macrophages, capillary proliferation, and early astrocytic reaction at the lesion edge
Chronic changes (months to years): removal of necrotic tissue by
macrophages with resulting cavitation (liquefaction necrosis); residual
reactive astrocytes form a gliotic scar at the infarct edges
Hypertensive Cerebrovascular Disease
Cerebrovascular disease associated with acute or chronic HTN
- Assoc c spontaneous intracranial hemorrhage and lacunar infarcts
~10% to 20% of all strokes; ~9 per 100,000 persons per year
~18,000 to 20,000 individuals in USA
Deep cerebral nuclei (putamen, thalamus): 60%
- Cerebrum (lobar): 20%
- Cerebellum: 13%
- Pons: 7%
Location of lacunar infarcts:
Basal ganglia in distribution of lenticulostriate branches of MCA, and periventricular and deep cerebral white matter
Up to 20% increased incidence in men; mean 60 years of age
Gross: acute cerebral hemorrhage of the deep nuclei, cerebellum, or pons; lacunar infarcts: basal ganglia, periventricular white matter, or both
Micro: Acute hemorrhage with acute blood clot and dissection through CNS tissue, sometimes with intraventricular or subarachnoid extension
-- Lacunar lesions may represent foci of ischemic infarction or widened perivascular spaces seen in the basal ganglia
-- Blood vessel: Hyaline arteriolosclerosis, lipohyalinosis, Charcot-Bouchard aneurysms (rarely observed in routine practice)
DDx: Lobar hemorrhage in patients with cerebral amyloid angiopathy or coagulopathies may mimic hypertensive hemorrhage.
Cerebral aneurysms (saccular /“berry” aneurysms)
Abnormal sac-like dilatations of cerebral arteries believed to be congenital in origin
- Ruptured aneurysms account for 25% of cerebrovascular deaths
- seen in ~7 to 10 per 100,000 persons per year
- up to 2% - increased with sized > 9 mm annual risk of rupture
- Multiple aneurysms ~1/3 patients
- Saccular aneurysms found in 6% to 9% of patients with arteriovenous
malformations (AVMs)
Arise at branch points of major arteries of the circle of Willis:
- Anterior cerebral–anterior communicating arteries: 40%
- M1-M2 divisions of the middle cerebral artery: 34%
- Internal carotid–posterior communicating arteries: 20%
- Basilar artery–posterior cerebral arteries: 4%
2F>1M; MC in adults >30 years, peak in the sixth decade, rare in kids
- Most aneurysms asymptomatic until rupture
-- Mild sx are occasionally related to an initial small bleed ("sentinel
hemorrhage")
-Acute aneurysm rupture results in severe headache with or without loss of consciousness
Gross: Thin-walled sac attached to arterial branch point via a narrow neck
- Spherical, oval, or lobulated sac; the rupture site may be apparent
- Rupture assoc c extensive basal subarachnoid hemorrhage
- Cerebral infarction due to arterial spasm
- Hemorrhage may extend into the ventricles
Micro: aneurysm sac c fibrocollagenous wall and may contain thrombotic or fibrocalcific material
Other forms of cerebral aneuryms
a. Fusiform – associated with atherosclerosis – may become "giant"
b. Infective ("mycotic") – includes all infectious forms – or just fungal
c. Traumatic
Arteriovenous Malformations (AVM)
Tangled mass of abnormal arterial and venous channels, without intervening capillaries, separated by gliotic brain parenchyma
- arteries and veins directly connect = high pressure lesions that bleed
Up to 4% of all brain masses
- Annual incidence of symptomatic AVMs is 1.1 per 100,000 persons
- Most AVMs located in distributions of major cerebral vessels:
middle cerebral artery > anterior cerebral artery > posterior cerebral artery (Uncommon: corpus callosum, choroid plexus)
- Optic nerve involvement in Wyburn-Mason syndrome
M=F; peak incidence in adults bwt 20 and 40 yo;
- mean age at diagnosis is about 30 years
- ~1/2 pts present c acute hemorrhage (typical of younger pts)
- may be a subtle onset of headaches and focal deficits
- Sx may occasionally be progressive because of AVM growth
- Cerebral angiography reveals a high-flow vascular lesion with arteriovenous shunting
Gross: Tangled mass of thick-walled blood vessels of varying caliber
- Superficial AVMs assoc cdilated draining veins on cerebral surface
- Deep AVMs drain into deep venous system
- may be evidence of remote or recent hemorrhage
Micro: thick-walled arteries, smooth muscle proliferation, fibrosis, and
reduplication of the internal elastic membrane
- Thick-walled “arterialized” veins
- Abnormal blood vessels may show thrombosis, recanalization, or evidence of previous embolization
- Gliotic CNS tissue between abnormal blood vessels
DDx: Highly vascular neoplasms; Other vascular malformations;
Px risk of acute hemorrhage is 2% to 4% per year
- risk of hemorrhage higher in pts younger than 45 years
- 2/3 patients with AVM have significant hemorrhage
- Immediate mortality with hemorrhage occurs in 10%
-Therapies include surgical resection, endovascular embolization, and
radiosurgery
Aneurysm of the Great Vein of Galen
Rare, congenital malformation of BVs that can cause High Output Cardiac Failure
- can present c developmental delay, hydrocephalus, seizure
- Great vein of Galen drains ant and central regions of brain into sinuses of posterior cerebral fossa
Cavernous Angioma
-aka cavernous malformation, cavernous hemangioma, cavernoma
Abnormal compact collection of thin-walled vascular channels without
intervening brain parenchyma and peripheral hemosiderin
- do not have arterial component or intervening brain
Annual incidence ~0.4% to 0.5%
- Occur anywhere in brain but typically involves cerebral cortex
- Supratentorial: 80%; infratentorial: 20%
~ 1/3 patients present with focal epilepsy
- Slight male preponderance; Young adults MC affected
Imaging: MRI features are PATHOGNOMONIC:
- Compact focus of increased vascularity with variable central density and peripheral hypodensity as a result of hemosiderin accumulation
- looks like "popcorn"
Micro: Compact mass of dilated, thin-walled blood vessels with no intervening brain tissue
b. Vessels may be calcified or thrombosed
- surrounding brain is gliotic and contains hemosiderin (bc is leaky)
Genes: Familial cavernous angiomas assoc c CCM1 gene mutations
(chromosome 7q11-21), usually in hispanic population
- encoded protein is KRIT1, which interacts c RAS family of
GTPases
- Other genetic loci: CCM2 (7p15-p13) and CCM3 (3q25.2-27)
DDx: Hemorrhagic tumor; Organizing cerebral hemorrhage
Px: excellent for surgically resectable, symptomatic lesions
Capillary telangiectasis
Incidental focal accumulations of dilated capillaries – found typically in subcortical white matter of pons.
- has intervening brain
- usually found at autopsy bc do not cause sx; very low pressure
Venous angioma
Sperficially located ―varicose veins‖ of cerebrum. These are
functional veins so not resected.
Cerebral Amyloid Angiopathy
- disorder characterized by deposition of B-amyloid peptide in the walls of cortical and leptomeningeal arteries, which predisposes patients to spontaneous lobar hemorrhage
~20 per 100,000 in patients >60 years
- up to 15% of cerebral hemorrhages in the elderly
- Hemorrhages in cerebral cortex and subcortical white matter
- Underlying cause of large "lobar" hemorrhages
M=F; MC in patients >60 yo; sx reflect anatomic extent of hemorrhage and range from massive lobar "stroke" to progressive dementia
- Parietal lobe involvement may result in contralateral "neglect" syndrome
- Commonly in demented individuals with Alzheimer-like neurofibrillary pathology
Micro: Acute massive lobar hemorrhage; Multiple cortical and subcortical hemorrhages of different ages; Leptomeningeal and cortical arteries show effacement of normal structure by
accumulations of amorphous AB-amyloid-immunoreactive material
- Late in the disease "double-barrel" contour of affected vessels
- White matter vessels rarely if ever affected
Gemes: Most sporadic and familial forms of CAA assoc c with deposition of AB-amyloid peptide (a cleavage product of the amyloid precursor protein encoded on chromosome 21)
- Abnormal protein folding results in B-pleated sheet conformation, which gives amyloid its optical characteristics
- Rare inherited forms of CAA assoc c mutations of genes encoding cystatin C, transthyretin, gelsolin, and prion protein
DDx: CNS vasculitis.
CADASIL (Cerebral Autosomal Dominant Arteriopathy with Subcortical Infarcts and Leukoencephalopathy)
Familial arteriopathy assoc c Notch 3 gene mutations and characterized by deposition of abnormal granular osmiophilic material in blood vessels walls
- Ischemic lesions of white matter and deep cerebral nuclei; T2-hyperintense lesions of white matter and deep nuclei
- presents c migraine headaches, transient ischemic attacks, and strokelike events, progressing eventually to dementia
Sx: Migraine with aura may be the initial symptom and appears most commonly in the third decade
- Ischemic attacks peak between 40 and 50 years of age
- clinical course usually progressive to dementia
- M=F; mean age of onset is 45 years;
- Cognitive decline between the ages of 40 and 70 years
Imaging: MRI shows multiple hyperintense lesions in periventricular white matter, basal ganglia, and brain stem
Gross: Lacunar infarcts of white matter and deep nuclei with ex vacuo
hydrocephalus; Usually little or no hemorrhage
Micro: Parenchymal arteries thickened and contain granular periodic acid–Schiff–positive material; Multiple foci of ischemic necrosis
- affected vessels can be found in the skin, such that skin biopsies may be used for dx
Ultrastructural Features are pathognomonic
Focal accumulations of granular osmiophilic material (GOM) bwt
vascular smooth muscle cells or within the thickened basal lamina are
virtually pathognomonic
- Skin biopsy with ultrastructural demonstration of GOM in deep dermal arteries has facilitated the diagnosis
Genes: AD, Point mutations or small deletions on the NOTCH3 gene (cr 19p13)
- Notch 3 protein is expressed in vascular smooth muscle cells and may normally promote cell survival, and sm muscle development
- Granular vascular material is reactive for Notch 3 protein
DDx: distribution of ischemic lesions similar to multi-infarct dementias (Binswanger‘s disease)
- Mitochondrial disorders such as MELAS (mitochondrial encephalopathy, lactic acidosis, and stroke-like episodes) may present a similar distribution of lesions
Demyelinating Diseases
Multiple sclerosis (MS)
Chronic demyelinating dz of CNS in 1/1000 US citizens, F>M, ~30 yo
- inflammatory demyelinating dz c multiple, randomly disseminated demyelinated lesions "plaques", as well as by chronic inflammation (lesions separated by space and time); dz active despite clinical remission
- genetic dz (assoc c HLA DR2), environmental (found more in tropical climates)
- lesions of MS are multiple, asymmetric, randomly distributed foci (plaques) of primary demyelination, (i.e., with relative preservation of axons). Dz most prominent in white matter of brain stem, spinal cord, optic nerves, cerebrum, and cerebellum. Periventricular plaques are quite common.
Acute lesions: Rapid breakdown of myelin with relative preservation of axons. Collections of foamy macrophages are prominent with reactive astrocytes at lesion periphery. Lymphocytes and plasma cells are usually found "cuffing" local small veins and venules. Creutzfeldt cells (multiple small micronuclei) are evident.
Chronic Lesions: Myelin has virtually been eliminated but a few axons can also be lost (especially with repeated episodes of demyelination. Macrophage reaction diminished.
Th cells activated and destroy myelin in CNS; assoc c HLA A3, B7, DR2, and DW2, MC demyelinating dz of CNS
- clinically waxes and wanes, usually have lesions of different ages
- women in 3rd to 4th decades
Marburg variant and Balos concentric sclerosis are variants
- Marburg variant is fulminant and can be confused c a neoplasm
Charcot's triad: *** drunk Ms Sin *** Scanning speach, Intention tremor / Incontinence, Internuclear ophthalmoplegia and Nystagmus
- peripheral nerves not affected, so look for someone c gait and focal sensory problems
- Marcus-Gunn pupils (MC in northern latitudes)
- preg assoc c dec relapse freq esp in 3rd tri
Uhthoff's phenomenon - sx get worse c heat (bath or warm H20 bc heat decreases conduction speed through demyelinated nerves even more
Imaging: plaques in periventricular white matter are classic ("Dawson's fingers")
Lab: Oligoclonal bands seen in 85% but not very specific, MRI of head and spinal cord is the best initial and most specific test
- oligoclonal bands indicative of intrathecal immunoglobulin synthesis
Gross: fresh, active plaques are round, edematous, bulging c ill-defined pink color; inactive "burnt-out" plaques are sunken, ell-defined, transprent, and better visualized than active plaques
- plaques seen in both grey and white matter (usually white)
Micro: Oligodendrocytic dropout and reactive gliosis in periventricular areas, although the axons are preserved
- areas of demyelination known as plaques, and can be found in cerebral white matter, spinal cord or brain stem
-- active (acute) plaques have dense lymphs and macrophages around vessels and in parenchyma, with swollen edematous axons
- chronic inactive plaques are densely gliotic c los of oligos and myelin and MC thin, naked axons, c little or no inflam
- periventricular white matter pallor can be highlighted c LFB
IHC: axons are spared, but is demyelinating
Tx: B-interferon or Glatiramer, lots of roids
- natalizumab may cause PML
Balo's Concentric Sclerosis
Rare demyelinating dz with concentric rings of demyelinated and relatively preserved white matter
- considered borderline multiple sclerosis
May be highlighted c Kluver-Barrera stain
Neuromyelitis optica (NMO; Devic's disease)
Lesions in spinal cord and optic nerves; this form may be, but is not always, rapidly evolving. 70-75% of patients have serum antibodies
to aquaporin 4 water channel. This molecule is located on astrocyte foot processes of the blood-brain barrier (BBB).
Acute disseminated encephalomyelitis
Postinfectious/Postvaccinal; Diffuse white matter perivenular petechiae
Acute necrotizing hemorrhagic leukoencephalopathy
Clinical course is more fulminant and rapidly progressive.
"Tumefactive" demyelination: "Demyelinating pseudotumor"
- Neuroimaging studies suggest glioblastoma! (large ring-enhancing mass); Pathologist must recognize features of demyelination
Alexander's Disease
- Inherited metabolic disease 2/2 mutations in GFAP gene
- Prominent Rosenthal fibers around blood vessels in white matter thoughout the entire brain
- Rosenthal fibers are densely compressed masses of glial intermediate filaments.
Rosenthal fibers: 3 etiologic classes
- Reactive Around low-grade tumors (eg, craniopharyngioma,
hemangioblastoma), Around cysts (eg, pineal, syringomyelia), Adjacent to any chronic compressive lesion or process
- Neoplastic: juvenile pilocytic astrocytoma
- Metabolic: Alexander‘s disease
Multiple sclerosis

Balo's Sclerosis

Progressive Multifocal Leukoencephalopathy (PML)





brain abscess

Neurosyphilis - inc plasma cells and endarteritis obliterans
Tabes dorsalis

Subacute Combined Degeneration of the Spinal Cord


SCDSC with degeneration of white matter in posterior and lateral funiculi of the spinal cord. The degenerated fibers lose their myelin and are thus unstained
Soap-bubble lesions c cryptococcus


Cerebral toxoplasmosis c cysts c tachyzoites


Coccidiomycosis
Histoplasmosis

Primary amebic encephalitis: extensive necrosis and hemorrhage, esp in frontal lobe

Naegleria fowleri: can look like macrophages
Granulomatous amoebic meningoencephalitis

Acanthamoeba

Herpes simplex encephalitis

CMV encephalitis


Negri body in an infected neuron
HIV "Giant cell" encephalitis

CJD

Spongiform encephalopathy

New Variant CJD (vCJD) with prominent "florid" ("daisy-like")plaques (fibrillary amyloid plaques surrounded by spongiform vacuoles) well visible already in this hematoxylin and eosin stain. Paraffin block given by courtesy of Dr. J. W. Ironside, Edinburgh. © H. Budka 2000


Watershed / boundary infarct, esp between the middle and anterior cerebral arteries

Embolic strokes are hemorrhagic
Hypertensive strokes, also hemorrhagic, usually occur in the basa ganglia


Saccular (berry) aneurysms

Cavernous angioma

AVM trichrome, has intervening brain that can be cause seizure

CADASIL - EM c GOMs

Multiple sclerosis - larger MS plaques are outlined in red and would be firm to the touch (the sclerotic part of MS)



Capillary telangiectasia

Cerebral amyloid angiopathy

Kernicterus



Wilson dz - KF ring

Globus pallidus c bilateral red discoloration from hyperemia, edema, and necrosis from Carbon Monoxide poisoning
Durck granuloma in cerebral malaria (P falciparum) infection, showing ring hemorrhage in the white matter

MS



Active / acute plaque in MS c lots of T-lymphs and foamy macrophages, astrocytes are sparse

Aneurysm of the great vein of Galen can cause high output cardiac failure


Cherry-red spot



MLD c loss of myelin

Methanol toxicity, c necrosis and cavitation of the putamen
Pediatric neuropathology
Neurodevelopment
1st 1. gestation the neural tube forms and closes, cranial nuclei and tracts for neuroblast prolif and migration
2nd 1/2 gestation: migration and diff of giral development, myelination
causes of developmental abnormalities
Abnormalities caused by molecular genetic factors, chromosomal abnormalities (teratogens, enc factors, rubella, CMV, maternal irrad, fetal alc syndrome and drugs, tobacco and nutritional deficiencies)
Gliosis does not occur before 20 WGA
Defects of neural tube closure (NTD)
MCC of CNS malformation; 2.2 defective neurulation, in first 3-4 WGA
Anencephaly
absence of all or part of the cerebrum, with rudimentary brain tissue "area cerebrovasculosa", and without skull. Incompatible with life
- have brain stem so can survive for a little bit
- rachischisis - most severe ntd, can be cranial caudal or combo of both - assoc c anencephaly
Encephalocele
less common than anencephaly but probably a part of the same dysraphic pathogenetic spectrum. It consists of a local, usually midline (and occipital) skull defect with portions of brain and/or meninges protruding. Px depends on amt of herniated brain tissue.
Meningomyelocele
a very common malformation in which there is a midline defect in spinal column (usually lumbosacral region) associated with protrusion of portions of spinal cord and/or meninges. Dysfunction of lower extremities and bowel/bladder are highly dependent on the amount of spinal cord involved in the lesion.
- meningeal cyst c portion of spinal cord
- herniation of cord through defect in vertebral arch (spina bifida)
- herniated sac has overlying usually darkly pigmented hairy skin lined by dura and c portion of spinal cord
- spinal cord c sac usually damaged
Meningocele -dysraphia leading to exposure or herniation of meninges but not of brain or spinal cord.
Spina Bifida Occulta -a localized, incompletely fused, dorsal vertebral arch of the spinal column. There is no herniation spinal cord or meninges. This is an asymptomatic form of NTD.
- All of above except spina bifida occulta can be detected prenatally by
measurement of maternal serum alpha fetal protein (AFP) and confirmed by ultrasound. Folic acid deficiency is a risk factor for neural tube defects. Risk is reduced by dietary folate supplementation during gestation.
Holoprosencephaly
Severe form of hypoxic-ischemic change where cerebral mantle (future cerebral cortex) severely attenuated into balloon-like structure
- caused by extensive ischemia of a major portion of cerebral mantle
- newborns c hydranencephaly have large heads
- a spectrum of malformations characterized by incomplete separation of the cerebral hemispheres reflecting a defect in diverticulation of prosencephalon to form telencephalic vesicles.
- Usually assoc c arrhinencephaly, where only olfactory bulbs and
tracts are absent (most mild type of holoprosencephaly)
- most severe form results in failure of separation of even the primordial eyes - cyclopia.
- Coexisting abnormalities of midline facial and underlying forebrain development (derived from the same developmental field) are thought to be the result of impaired induction by prechordal mesoderm. Thus, both cerebral diverticulation and development of midfacial structure, respectively, are disturbed. (i.e. "The face predicts the brain.").
- Multifactorial etiology: 7/10 c Trisomy 13 (Patau‘s) patients have holoprosencephaly, also assoc c Trisomy 18
- Increased incidence with maternal diabetes, toxoplasmosis, syphilis and rubella.
- Mutations in the sonic hedgehog (SHH) gene, which encodes a secreted protein regulates neurodevelopment, have been associated with some cases of holoprosencephaly.
Posterior fossa/cerebellar malformations
Arnold-Chiari Malformations
Second MCC brain malformation (after neural tube defects) and most common cause of congenital hydrocephalus. Etiology and pathogenesis are poorly understood.
Chiari II is MC form.
- a complex lesion involving cerebellum, spinal cord, cerebrum
- herniation of cerebellar tonsils, downward shift of brain stem, flat pons, pons malformation consisting of shallow post fossa c platybasia, meningomyelocele, hydrocephalus and polymicrogyia
- The cerebellar tonsils are developmentally elongated or displaced caudally, along with caudal medulla, through foramen magnum into upper cervical canal.
- Dorsal "S"-shaped "fold" at cervicomedullary junction.
- Midbrain "beaking". Associated dorsal distortion or malformation of
midbrain tectum, with or without an accompanying aqueductal stenosis.
- Hydrocephalus. A very common (but not universal) feature.
- usually assoc c spinal bifida or meningomyelocele
- Craniolacunia (patchy thinning of the calvaria) in up to 90% of cases
Chiari I:
- Rare cause of late onset hydrocephalus in adults.
- Elongated cerebellar tonsils extend through foramen magnum.
- 50% of Chiari I patients have syringomyelia; 90% of patients with
idiopathic syringomyelia have a Chiari I malformation.
Chiari III: Very rare; occipitocervical encephalocele (posterior occipitocervical bone defect with herniation of the cerebellum through the defect into an encephalocele)
Chiari IV: Very rare; hypoplastic cerebellum
Dandy-Walker Malformation
uncommon malformation of midline cerebellum,assoc c abnormal (possibly hypoplastic) vermis and characteristic cystic dilatation of the 4th ventricle
- F>M, may be assoc c exposure to rubella, CMV, toxoplasmosis, warfarin, alcohol, isoretinoin
- assoc c characteristic occipital skull abnormality.
Neuronal Migration Abnormalities
- Often associated with SEIZURES.
Agyria / Pachygyria
- either absence of gyri or presence of few abnormally broad gyri, respectively; plus associated abnormality of cortical cytoarchitecture.
- relatively smooth surface of brain called "lissencephaly"
- "lissencephaly syndrome" is seizures and mental retardation, (Miller-Dieker syndrome), about 9/10 pts c deletions of LIS1 gene, cr 17
Polymicrogyria
"Many small gyri" c abnormal cortical lamination.
- Heterogeneous etiology: intrauterine ischemia, infection; multiple genetic assoc
Agenesis of the corpus callosum
- Absence of both corpus callosum AND cingulated gyrus
- "Bat-wing" appearance of lateral ventricles on coronal view
- May be asymptomatic or associated with other CNS/systemic abnormalities such as Aicardi syndrome (X-linked dominant), Walker-Warburg syndrome (X-linked dominant), Meckel Gruber syndrome (AR), Miller Dieker syndrome (lissencephaly syndrome), Neu-Laxova syndrome(AR), Septo-Optic dysplasia sequence, Zellweger syndrome (AR)
Heterotopias
Displaced nodular or laminar (linear) masses of neurons found in the
white matter or at periventricular sites. These may occur at any point along the path of neuronal migration.
- may be related to radiation exposure (?)
Syringomyelia (non-traumatic)
Cystic cavitation of the cervical spinal cord.; Uncertain etiology; Clinical onset in young adulthood (2nd – 3rd decade) with motor weakness of limbs and trunk, spinal column deformity
- 9/10 of idiopathic cases have an associated Chiari I malformation.
Hydrocephalus
Ventriculomegaly usually 2/2 obstruction of CSF flow (overproduction of CSF can also be a rare cause -i.e. choroid plexus papilloma). In
congenital hydrocephalus, the abnormality can result from an underlying malformation or from a disruption in the development of the aqueduct of Sylvius, or hindbrain.
- if Open cranial sutures -head enlargement.; Closed sutures inc intracranial pressure earlier and more severe, may lead to herniation.
- Hydrocephalus can represent the effect of a malformation (Aqueductal atresia/stenosis; Arnold-Chiari Malformation) or an extrinsic or acquired defect (Gliosis of aqueduct and resulting stenosis due to prenatal inflammatory or hemorrhagic process; Meningitis with organization and obliteration of subarachnoid space; Neoplasm with direct or indirect occlusion of aqueduct, IIIrd, or IVth ventricle; or Dural sinus thrombosis with obstruction of CSF reabsorption)
Acquired Perinatal Brain Injury
- "Cerebral palsy" is a clinical term that refers to any nonprogressive neurological motor deficit that was acquired during the perinatal period, regardless of etiology. Some causes:
Germinal Matrix Hemorrhage/Intraventricular Hemorrhage.
in premature, low birth weight infants < 34 wks ga, (rarely at term) and SBs as young as 2 wks
- occur w/in 48 hrs post-partum, range of 6 hrs to 8 days
- hemorrhage in in periventricular germinal matrix over head of caudate or thalamus
assoc c IRDS, coagulopathies, congenital heart dz
2/2 fragile microcirculation in germinal matrix and failure of autoregulation during hypoxic stress
- matrix zone is composed of primitive neuroepithelial cells and contains delicate capillary-like vessels which are tributaries of the deep venous system. Rupture of the latter in a stressed premature infant produces characteristic hemorrhages.
Can be graded from 1-4 (1 is confined to germinal matrix, 4 is hemorrhage of germinal matrix extending into adjacent cerebral parenchyma)
- In premature infants, there is an increased risk of parenchymal hemorrhage within the germinal matrix zone, located between the thalamus and caudate nucleus.
- Extension of hemorrhages into the ventricular system may lead to death in the acute stage or to chronic hydrocephalus.
White Matter Necrosis
Periventricular leukomalacia (PVL) refers to ischemic infarcts of the
periventricular white matter; probably due to hypoxia or hypoperfusion of vulnerable tissues, either 2/2 intrinsic properties of vulnerable tissue (the developing white matter) or local patterns of vascular supply, (i.e., the periventricular white matter is a "watershed" area)
- may progress to multicystic encephalopathy
Term babies (5%) mainly but also premies (24-32 WGA) at high risk
- pathogenesis: impaired perfusion at boundary zones where metabolic requirements of white matter are highest
Focal or diffuse softening (from infarction) of periventricular white matter
Micro: foci of necrosis in periventricular regions surrounded by diffuse, reactive gliosis and microglial activation
- older lesions have cavitation, a microcystic parenchyma and calcifications; glial scars can form in previous necrosis
Complications: secondary hemorrhages into infarcted areas
- cavitation or scarring
- can lead to cerebral palsy
May be related to Idiopathic Respiratory Distress Syndrome (IRDS)
- Well-circumscribed chalky-white foci in white matter of centrum semiovale adjacent to lateral ventricles, esp. supero-lateral to lateral angles of the lateral ventricles
- PVL is commonly associated with spastic diplegia, which is a common clinical finding in cerebral palsy
Multicystic encephalopathy
Multiple cysts-like transformation of the deep cerebral and brain stem structures
- involve mainly white matter and white/gray matter interfaces
- occurs as a result of third trimester anoxia
- may present as a fetal, perinatal or neonatal lesion
Hydranencephaly, porencephaly and multicystic encephalopathy all likely a result of hypoxic-ischemic injury rather than a primary genetic defect
Gray Matter Necrosis
Occurs mainly in term infants
- ponto-subicular necrosis or cerebral and cerebellar necrosis
Perinatal ischemic lesions of the cerebral cortex typically affect the depths of the sulci. This is called ulegyria (Club-shaped or mushroom-like gyrus due to sparing of gyral crowns)
Status marmoratus: Neuronal loss and gliosis in the thalamus and basal ganglia plus aberrant myelination in these areas produces a "marbled" appearance of the deep nuclei. Damage to the caudate, putamen, and thalamus may result in movement disorders.
Cerebral cortical dysplasias
- aka Focal Cortical Dysplasia (FCD?)
Cortical dysplasia are malformation of cortical organization, can be either localized or multifocal
- MC in the frontal and temporal lobes
- the younger the child that the brain tissue is removed from, the more likely it is more severe
- can be differentiated into 3 subtypes
Gross: often unremarkable, though may see cortex lacking sulci, thickening of the gyri, blurring of the gray-white matter junction
Micro: hypercellular cortex c disruption of the normal lamination and neuronal polarity
- heterotopic nerve cells in molecular layer and inc neurons in underlying juxtacortical white matter
- bizarre cytomegalic nerve cells up to the size of Betz cells c cytoplasmic fibrillary inclusions similar to the tangles in Alzheimer dz c inc branching and arbors of dendritic processes seen on Bielchowsky stain
- balloon cells c abundant glassy cytoplasm and astrocyte-like morphology (resemble gemistocytic astrocytes) which have 2+ nuclei or a partly reduplicated nucleus c a nuclear bridge and variably prominent nuclear eosinophilic inclusions
- can also see subpial layers of myelinated axons, reactive gliosis, subpial fibrillary ("Chaslin") gliosis, inc corpora amylacea
- may be assoc c tumors (pilocytic and fibrillary astrocytomas, DNTs, and gangliogliomas)
IHC: balloon cells GFAP+ (have intermediate cytoplasmic filaments)
DDx: cortical tubers (FCD has no systemic or cutaneous stigmata of tuberous sclerosis, and does not have subependymal lesions or calcifications, FCD also presents c epilepsy at an older age than TS, and a "wheat-sheaf" appearance of astrocytes in subpial region is typical of tubers)
Down syndrome
MCC MR
Short frontal lobes and small superior temporal gyrus
Micro: unremarkable c HE, sparseness of synapses on silver stain
Have propensity for early onset Alzheimers
Cause leukemia and cardiac malformations
Fragile X
2nd MCC MR, trinucleotide repeat on FMR1 gene (Xq27); microcephaly c neuronal heterotopias
Porencephaly
- fistula in cerebrum that connects subarachnoid space c the ventricle
- margins of the pore show microgyria,
- at most severe is called schizencephaly or basket brain
- caused by ischemia
Subpial hemorrhage
Due to asphyxia, prematurity, congenital heart dz
Kernicterus
deep staining of gray matter hippocampus and brain stem nuclei
Due to unconjugated hyperbilirubinemia
- follows asphyxia, acidosis, septicemia, in small pre-term babies c inc bilirubin (even 10 mg/dL)

Anencephaly
Holoprosencephaly - single large ventricle c fusion of the midline structures, including thalami. Inset shows midline facial abnormalities


Arrhinencephaly - missing olfactory bulbs



Dandy-Walker; cyst wall has ruptured and there is no cerebellar vermis

Germinal matrix hemorrhage

PVL


Cerebral cortical dysplasia

References
1. Dr. Rhagavan lecture notes
2. Osler notes
